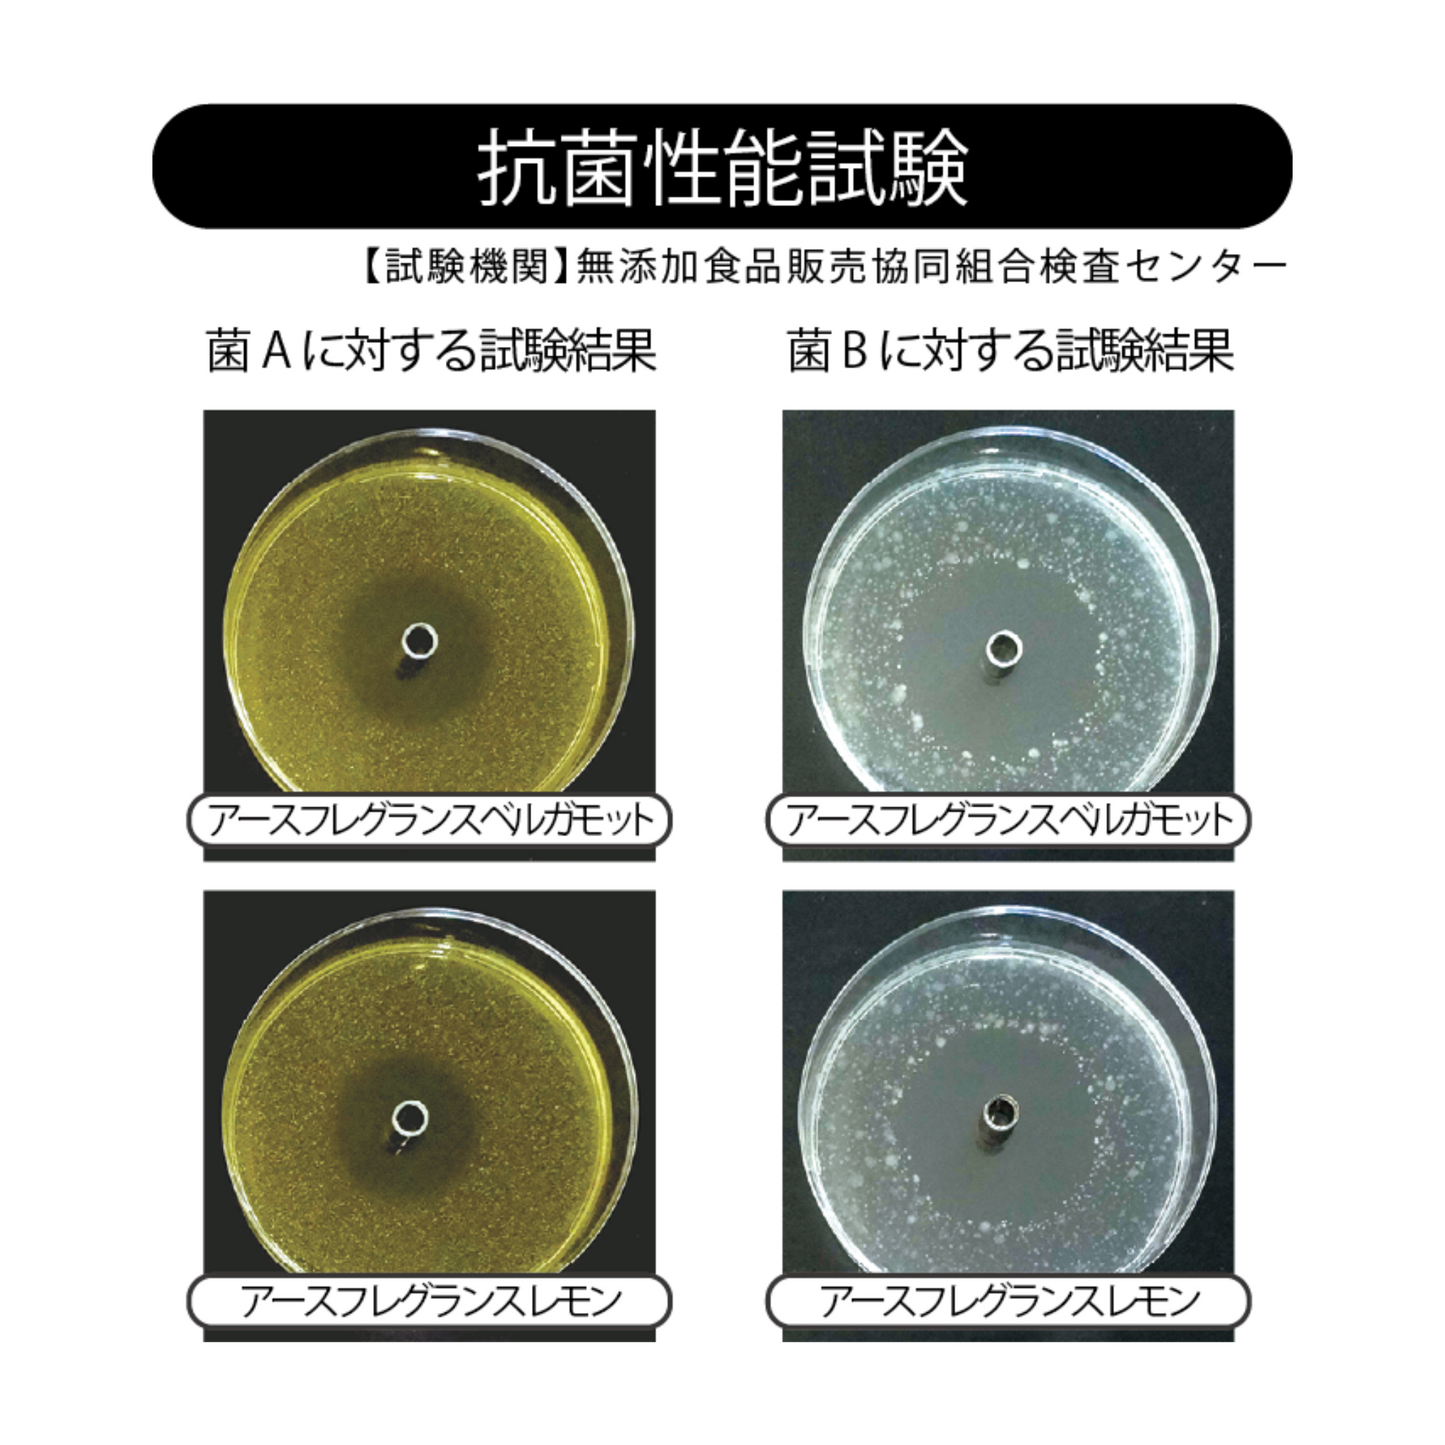

RISE SUPPORT
アースフレグランス ストレートクリア レモン
アースフレグランス ストレートクリア レモン
受取状況を読み込めませんでした
家の中を森にする地球の香水
化学薬品や機械・器具に頼らず、バイオの力と天然由来のアロマで生活空間にくつろぎの森を創出する”地球の香水”です。
アースフレグランス ストレートクリアは、自然環境にいる乳酸菌や酵母菌などの有用微生物だけを集め培養した【アール菌(R菌)】を主体とする住空間用の抗菌・消臭アイテムです。
R菌とR菌が醸し出す乳酸菌生産物質が有機物の腐敗菌繁殖を抑え、悪臭やヌメリなどの不快な環境を抑制します。バイオ(微生物)の力と天然由来のアロマオイルが室内を爽やかで有用菌優位な快適空間に導きます。
*アール菌(R菌)とは
5つのグループの乳酸菌・酵母菌などで構成された有用複合菌です。
優れた特徴として、悪玉菌の繁殖を抑え、善玉菌優位にする働きがある有用菌で、化学薬品や抗生物質等を使用せずに、私たちの身の回りの環境を整えることができます。
アール菌(R菌)のルーツとなる微生物の複合菌の研究は約100年前から始まりました。豊かな土壌ほど数多くの微生物が存在することが発見され、生活に役立つ菌が採取・培養され有用複合菌が作られるようになりました。
やがて、土壌改良だけでなく、生活環境改善、食品発酵など、様々な分野でその威力を発揮し、現在に至っています。
アンモニア脱臭(消臭)試験

『試験機関』無添加食品販売協同組合検査センター

『試験機関』無添加食品販売協同組合検査センター
アースフレグランス ストレートクリア(レモン・ベルガモット)の抗菌試験では、2種類の菌を用いて、ハロー菌(菌が生育していない部分)の有無を確認しました。その結果、いずれの菌に対してもハロー菌が観察され、抗菌性を有することが確認されています。
《ご使用方法》
◎スプレイヤーに使用分を入れ、リビングや寝室、タバコのニオイ、靴や靴箱、トイレの使用後、お部屋に残ったペットのニオイ、自動車の車内、ゴミ箱など、気になるニオイに散布してご使用ください。
【ご使用上の注意】
◎必ず単独でご使用ください。アースフレグランス ストレートクリアはバイオの力を活用し、また、酸性の性質のため塩素系(強アルカリ性)の製品と併用しないでください。
◎人体、植物への直接噴霧はおやめください。
◎ペットへのご使用はおやめください。
◎この商品は飲料用ではありません。
◎蓋はしっかり閉め、開けたままにしなでください。
◎スプレイヤー、アトマイザーに入れる際に液が飛び出すことがあります。目に入らないに注意してください。目に入った場合はすぐに水で洗ってください。
◎原液が皮膚についても特に支障はありませんが、皮膚の弱い人や傷口についた場合は水でよく洗ってください。
◎微生物の活性によりニオイにバラつきがあることや、浮遊物もしくは沈殿物が発生することがあります。品質には問題ございませんので、使用の際には良く振ってください。
◎お子様やペットの手の届く所に置かないでください。
◎保管条件によっては、品質保持期限内であっても変色したり、腐敗臭や浮遊物、賃貸契約の極端な増加が生じることがあります。このような場合は、本品の使用をおやめください。
◎この商品には生きた微生物が含まれているため、菌の活性によりパッケージが膨張する場合があります。
《保管方法》
◎直射日光を避けて、冷暗所で保管してください。
◎開封後は立てた状態で保管してください。
成分 :有用微生物・産生物混合液・アルコール・クエン酸・エッセンシャル
用途 :一般家庭用
内容量:1,000ml
品質保持期限:製造日より1年間
共有